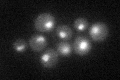
YEL018W
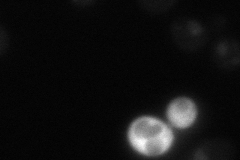
YEL018W
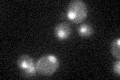
YEL018W

View description
Esa1p-associated factor, non-essential subunit of the NuA4 acetyltransferase complex
Localization:
Intensity:
Fold change:
Significance:
-
C’ GFP library in SD
nucleus29.46 -
N' NOP1pr-GFP in SD

nucleus37.7787 -
N' TEF2pr-mCherry in SD

nucleus13.8994 -
N' NATIVEpr-GFP in SD
nucleus26.134 -
N' TEF2pr-VC and Cyto-VN in SD

below threshold24.8909 -
C’ GFP library in SD+DTT

nucleus28.110.95No -
C’ GFP library in SD+H2O2
nucleus30.671.04No -
C’ GFP library in Starvation Media

nucleus21.520.73Yes -
C’ GFP library on the background of Pup2-DaMP

nucleus -
C’ GFP library on the background of CCT mutant

nucleus30.95771.05059No
